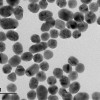
Nanoparticules d'or vues au microscope électronique

Certains médicaments utilisent des nanoparticules comme support d’un principe actif. Bien qu’une réglementation stricte s’applique au produit fini, les critères de qualité des nanoparticules employées restent à établir : taille, forme, régularité d’un lot ou présence d’impuretés…
Intervenants : Arnaud Pallotta, maître de conférences & Jordan Beurton, doctorant
Laboratoire Cible Thérapeutiques et Formulation – CITHÉFOR (Université de Lorraine)
Déroulé de la soirée :
- Intro : Que savez-vous des nanoparticules et de leurs utilisations ?
- Discussion : Du médicament classique aux nano-objets. Exemple d’une recherche appliquée aux maladies cardiovasculaires.
- Animation : Nous souhaitons développer un nouveau médicament à partir de nanoparticules d’or. Notre fournisseur, nous annonce des nanoparticules sphériques, de taille constante et de concentration bien définie.... Aidez-nous à en contrôler la qualité !
- Jeu de rôles : Serez-vous pro ou anti-nano ? Industriel, chercheur ou bien médecin homéopathe ? Peu importe votre camp, il vous faudra argumenter.
Soirée organisée dans le cadre de l’opération À votre Santé et de l’Année de la chimie.
Entrée gratuite, réservation obligatoire via www.pintofscience.fr